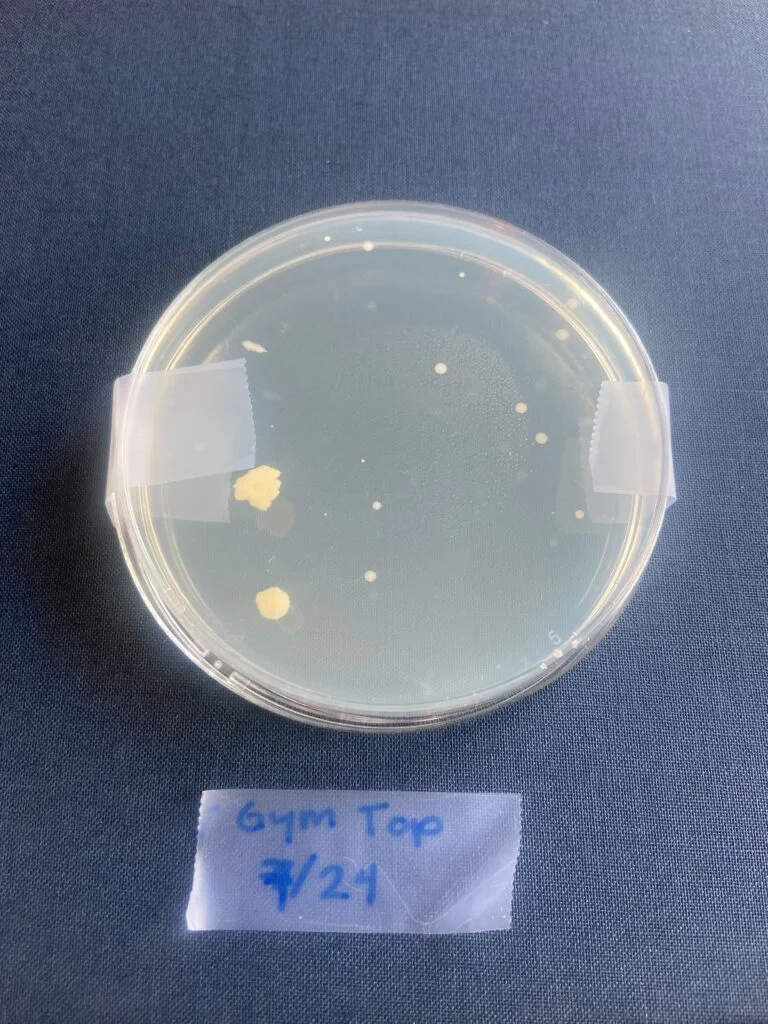
IMG 5500
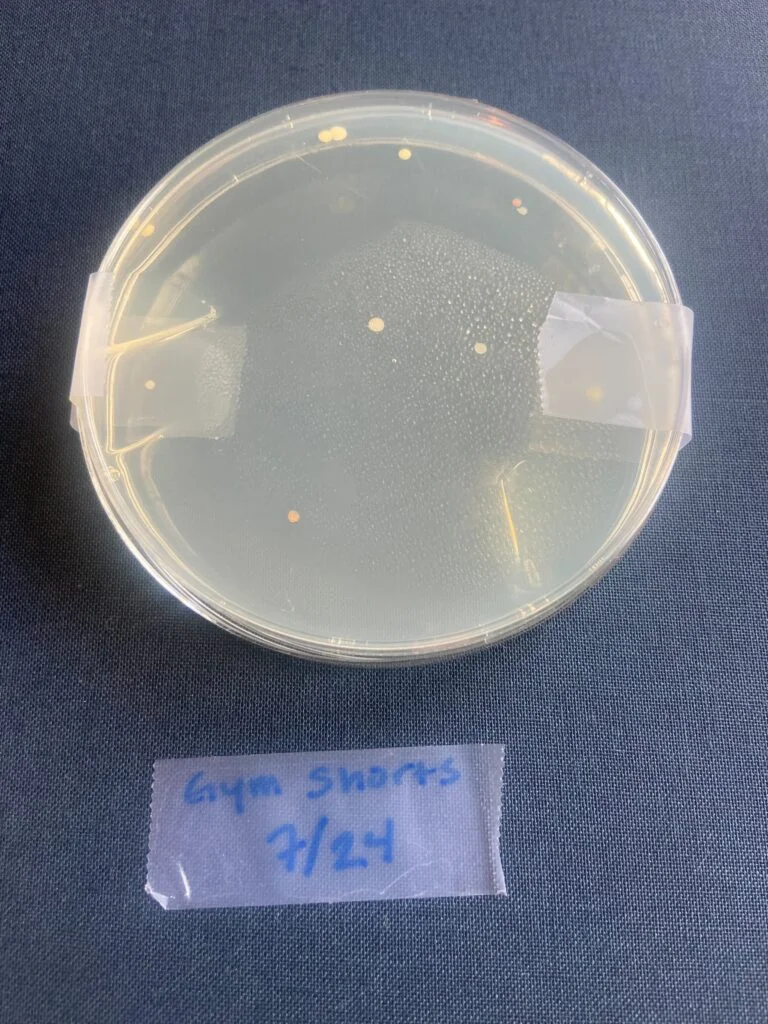
IMG 5502
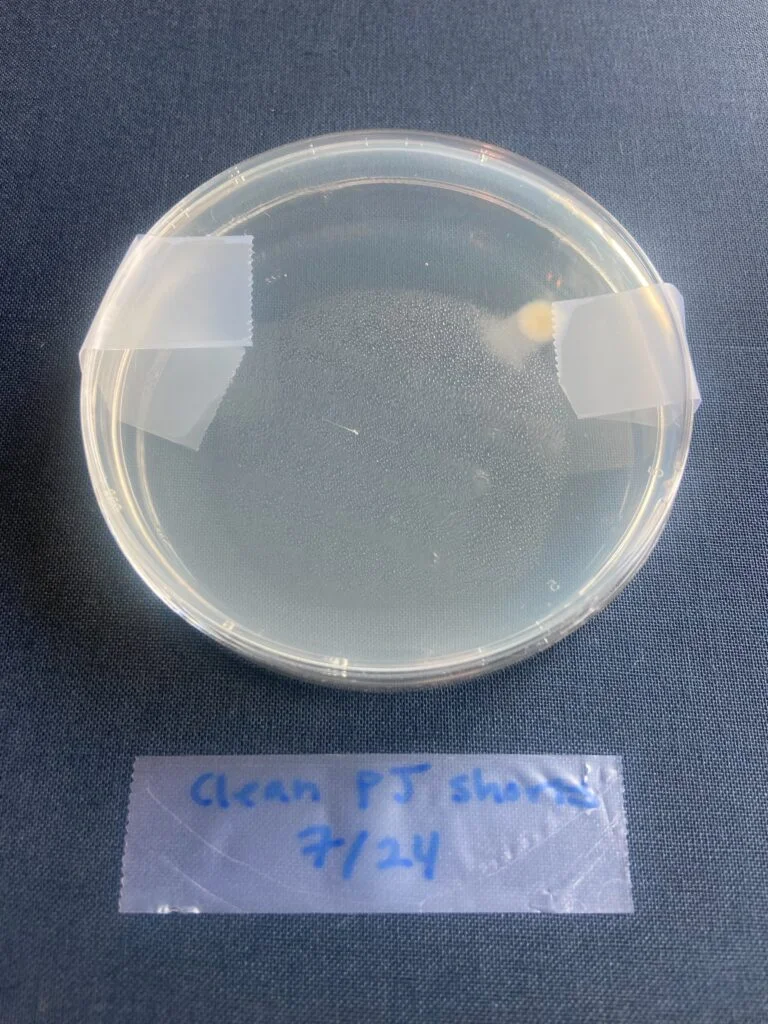
IMG 5504
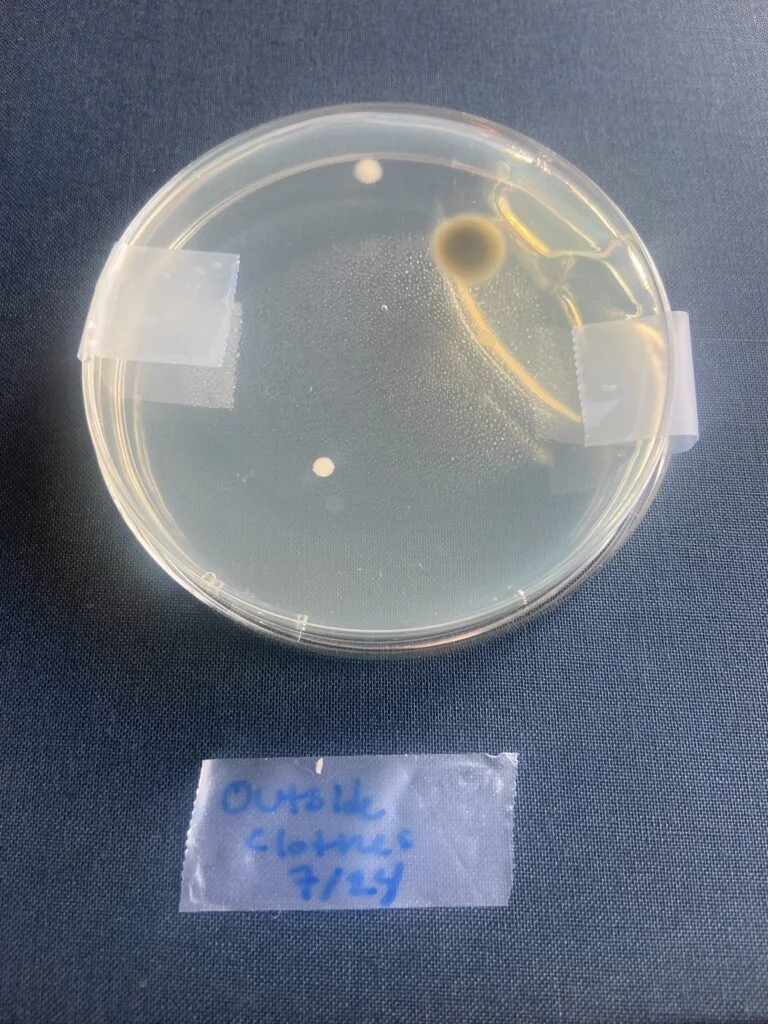
IMG 5508
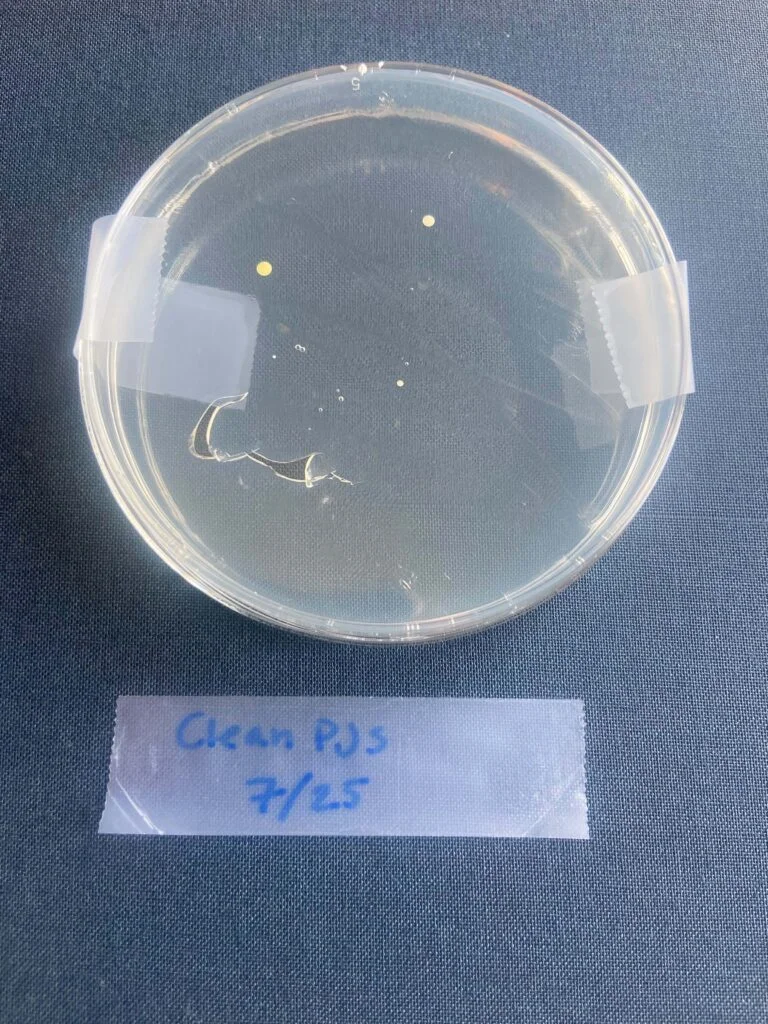
IMG 5515
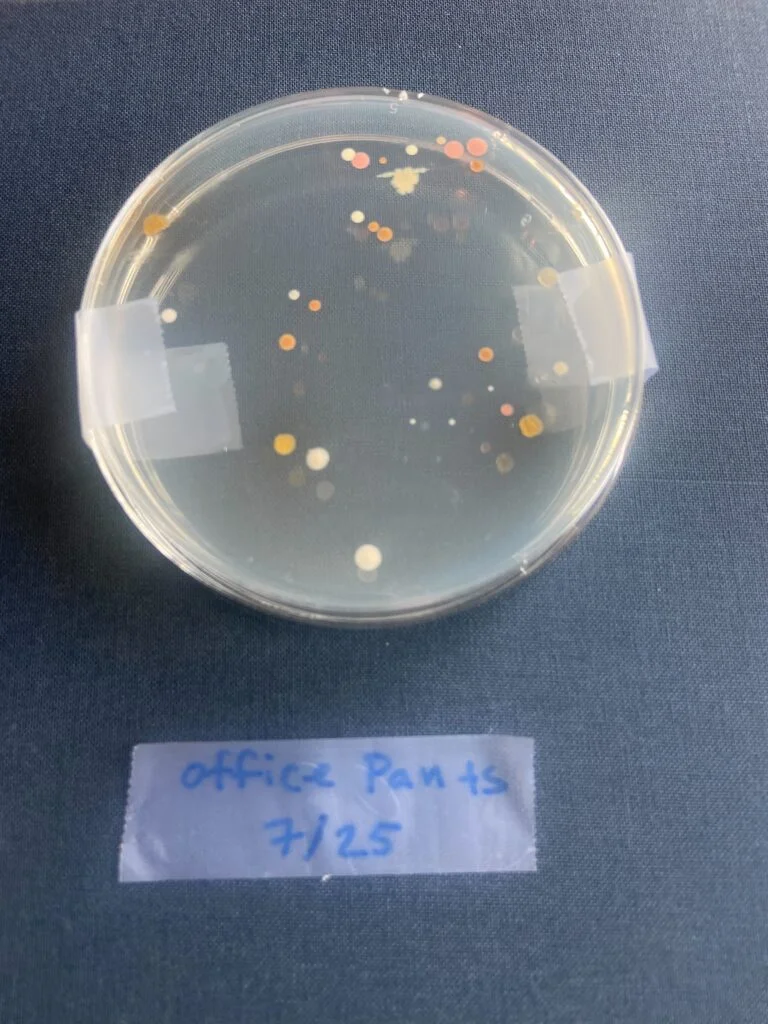
IMG 5513
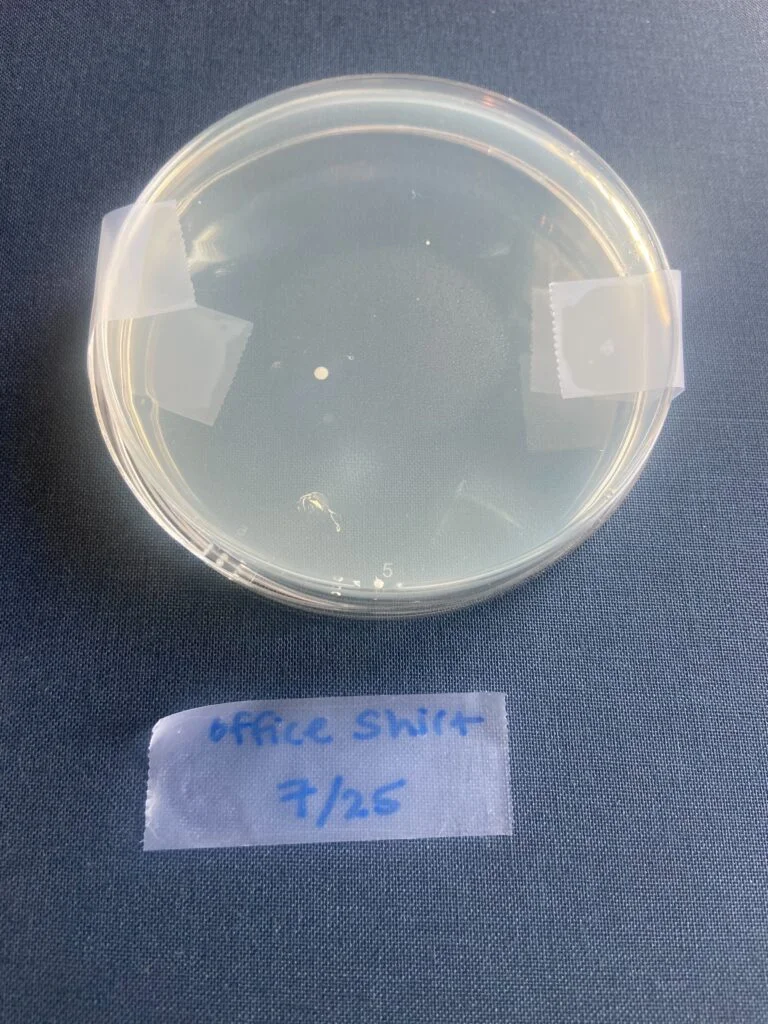
IMG 5511

Does the thought of flopping onto your bed in your work clothes the moment you get home give you the major ick? Or maybe you’re not the type to consider your attire before lying down in bed? Either way, there seems to be a strong divide between those who take issue with “outside clothes” making contact with their bed and those who don’t.
This debate about outside clothes in bed seems to be one of those recurring topics I hear from friends and see online over and over again. Admittedly, I’m the second type of person — I’ve gone most of my life laying down in my bed for a nap or to lounge in just about any clothes (save anything noticeably dirty or sweaty gym clothes). But the debate got me wondering if I was inadvertently doing something really gross and if there was any real health risk posed by this behavior.
So I decided to dive in and find out what exactly the deal is with wearing outside clothes in bed.
How Do People Really Feel About Wearing Street Clothes in Bed?
First things first, I wanted to get a sense of how people are divided on this issue. I personally know people on both sides, but just how strongly do people feel about wearing street clothes in bed, broadly?
Sleepopolis sent out a survey through CloudResearch’s Connect and received responses from 300 Americans regarding their thoughts on wearing outside clothes in their bed. Let’s take a look at the results.
A solid majority of respondents — 64.7 percent — said they did have some opposition to wearing street clothes or “outside” clothes in their bed.
When asked how often they change out of street clothes before getting in bed, 43.3 percent of respondents said “Always,” most closely followed by 30.3 percent of respondents saying “Most of the time.” The lowest percentage of respondents said “Never” — only 9 percent.
When asked how likely respondents are to change out of street clothes to lay down for a nap or to rest, 42.7 percent of respondents said “Very likely,” representing the majority. The next largest group was 21.3 percent of respondents, who said “Likely.”
Finally, when asked how strongly respondents agreed with the statement “Clothes worn outside the house are too dirty to wear in my bed,” 28 percent of respondents said they “Strongly agree,” while 21.3 percent said they “Agree.” Another 23 percent of respondents said they “Somewhat agree,” while 22 percent of respondents said they “Disagree.”
While there is some variation within the results, they overall seem to suggest that many Americans tend to change out of street clothes before getting into bed, or at least believe that you should.
Just How Dirty Are My Clothes?
All these different opinions on the cleanliness of clothes had me curious: just how dirty are my clothes? I decided to run a little at-home experiment — yes, a petri dish is involved!
Armed with my memories of AP biology and a bacteria growing kit from Home Science Tools, I set out to see how much bacteria would grow from swabbing clothes worn outside and clothes fresh from my dresser. (Disclaimer: I’m a writer, not a scientist! I followed the instructions that came with my kit as closely as possible, but this is more like your kid’s science fair project than a conclusive scientific study.)
Let the Experiment Begin
I took samples from two different days and let them sit for a week to see what would grow. From the first day, I swabbed a clean pair of pajama shorts straight from my pajama drawer for my “clean clothes” sample. For dirty “outside” clothes, I swabbed both my gym clothes and the clothes I wore out later that day to an outdoor fast food spot that isn’t known for being super clean.
Unsurprisingly, my gym clothes turned up the most bacteria from clothes I swabbed on the first day. The clothes I wore to the fast food restaurant also turned up a bit of bacteria growth. But my “clean” PJ shorts weren’t totally in the clear — I did see a small amount of bacteria growth from them.

For my second day of swabbing, I tested yet another pair of clean pajama pants right out of my drawer. I wanted to get some variety in clothes worn in out-of-the-home locations, so I decided to swab my boyfriend’s clothes when he came home from work. He works in a decently large office, so I figured this would be a great test. That same day after work, we also went over to a friend’s apartment for a game night, so I decided to swab the clothes I wore to see what the results would be from walking over there and spending a few hours in a different location with a larger group of people.
The results from my second day of swabs were very interesting to me. My clean PJ pants resulted in a small amount of bacteria growth, similar to the PJ shorts from the day before. And my “outside clothes” worn to my friend’s game night didn’t grow much at all. But the petri dish I swabbed from my boyfriend’s work pants turned up some of the most bacteria growth from the entire experiment — it was also the most colorful. Interestingly, his work shirt didn’t have nearly as much growth.

Experiment Takeaways
Overall, I wasn’t too surprised by the results of my experiment. I definitely expected my clean pajamas to have less bacteria growth than the dirty clothes that my boyfriend and I had worn outside the house. It also made sense to me that his office clothes and my gym clothes had the most bacteria growth. However, I was a little surprised at how little bacteria growth there was in general — I did this same type of experiment in my high school biology class and we swabbed everything from door handles to toilets to our phones, and I remember growing much more bacteria in those petri dishes than my clothes-swabbing resulted in.
With the insight that perhaps my out-of-the-house clothes are a bit dirtier than my freshly cleaned pajamas, I decided to dive into the real science of bacteria on clothes and just how much of a problem it poses to your health if it makes contact with your bed.
How Bad Is It Really to Wear Outside Clothes in Bed?
Clearly, many people believe it is better not to wear outside clothes in bed, and my own little at-home experiment could seem to confirm those beliefs. But is there any real risk? Or is it more of a mental ick?
While clothes can pick up and spread germs, in most cases, the risk they present is low. (1) “The main reason not to sleep in outside clothes is discomfort,” Robert Philip Lindeman, MD, Ph.D. tells Sleepopolis. “I know of no particular infectious risk of doing this.”
He says there is not much concern about bacteria or viruses from clothes that have been outside. Sean Marchese, MS, RN from The Mesothelioma Center echoes this, telling Sleepopolis that, “In most cases, and for most people, getting sick from your clothes alone is rare.”
“For highly contagious diseases, such as the flu or COVID-19, the infection occurs when someone carrying the virus talks, sneezes or coughs into the air you breathe,” Marchese says. “It can also transfer via droplets on surfaces you touch, but these droplets are likely to dry or evaporate from your clothes by the time you get home.”
Plus, most healthy people’s immune systems are strong enough to ward off any potential harm from bacteria or pathogens that may have lodged onto their clothes while out of the house. “It is safe in terms of infection because your body—and its normal bacteria—are capable of fighting off [these] threats,” Nasia Safdar, MD, Ph.D., tells Martha Stewart. (2)
When to Be More Cautious
However, there are some instances where caution with dirty clothes is necessary.
Elderly and Immunocompromised People
Marchese points out that older adults or immunocompromised people may be at greater risk from dirty clothes than most people. “Transferring even low amounts of allergens or infectious material to your furniture or bed can risk disease in those with compromised immune systems,” Marchese says, “Bringing outside clothes into a clean house can endanger those with open wounds, cancer, or autoimmune diseases.”
He recommends bringing a change of clean clothes if you are living with or visiting someone who can quickly get sick to help prevent any dangerous spread of germs.
Hazardous Work Environments
Marchese also recommends more caution if you have been exposed to an environment with hazardous materials, such as asbestos or residue from poisonous plants. “Consider your surroundings if you know you’ll be in a hazardous environment, and check your clothes for contamination before leaving the site,” he says. “Always follow guidelines for wearing Personal Protective Equipment.”
The same logic applies to healthcare workers and food service or preparation workers (1). If you spend a lot of time in a workplace or other area where you might be exposed to known pathogens or harmful substances, it’s probably a good idea to change out of your clothes before hitting the hay.
People with Allergies
If you or someone you share a bed with suffer from seasonal allergies, it’s also a good idea to ditch your outside clothes once you get home. The American College of Allergy, Asthma, and Immunology recommends taking a shower, washing your hair, and changing clothes after working or playing outdoors as a possible way to avoid allergy triggers. (3)
Exposure to Ticks
Lindeman also points out that not changing out of your outside clothes can prevent a risk for tick-borne illness, since ticks can get under your clothes. However, he says a simple tick-check after coming in from outside in an area of high prevalence of ticks can do the trick. So basically, even if you’re exhausted after your hike, take a few minutes to change and check yourself for ticks before resting up in bed.
How to Protect Yourself
The answer is probably more obvious than you think: basic hygiene. According to the United Kingdom’s National Health Service, regularly washing your hands is “likely to be significantly more important than clothes washing at preventing most infections.” (1)
Additionally, be sure to wash most of your clothes on a regular basis and wash any high-risk items in hot water. The NHS’s high-risk items include clothes soiled with vomit or feces, sports clothes, clothing worn over a wound or infected skin, farmers’ clothing, healthcare workers’ clothing, and food prep workers’ clothing.
Another key way to keep your bed clean? Wash your sheets! Your bedding can trap sweat and skin cells that feed dust mites even if you go to sleep in fresh PJs every night, so be sure to wash your sheets about once a week.
Final Thoughts from Sleepopolis
All in all, it’s best to sleep in whatever clothes are most comfortable to you. As long as you aren’t wearing any high-risk items, it seems you won’t be facing any major health risks by taking an after-work nap in your street clothes. But there’s also nothing wrong with taking the time to change into fresh PJs, if that’s what makes you feel most at peace to rest.

Lyocell vs. Cotton Sheets — Differences and Benefits

How To Sleep Better During Allergy Season

30-Day Sleep Hygiene Plan

Can’t Sleep? Check Out Our Expert Sleep Tips
Sources
- NHS Choices. (2019). Can clothes and towels spread germs? NHS. https://www.nhs.uk/common-health-questions/infections/can-clothes-and-towels-spread-germs/
- Buiano, Madeline. “67% of Our Readers Think It’s Unsafe to Sit on Their Bed in Outside Clothes—a Doctor and Laundry Expert Settle the Debate.” Martha Stewart, 8 Aug. 2022, www.marthastewart.com/8298064/can-you-wear-outside-clothes-in-bed
- American College of Allergy, Asthma, & Immunology. “Seasonal Allergies | Causes, Symptoms & Treatment.” ACAAI Public Website, 28 Dec. 2017, acaai.org/allergies/allergic-conditions/seasonal-allergies/
- Lindeman, Robert. Personal Interview. 13 July 2024.
- Marchese, Sean. Personal Interview. 12 July 2024.
